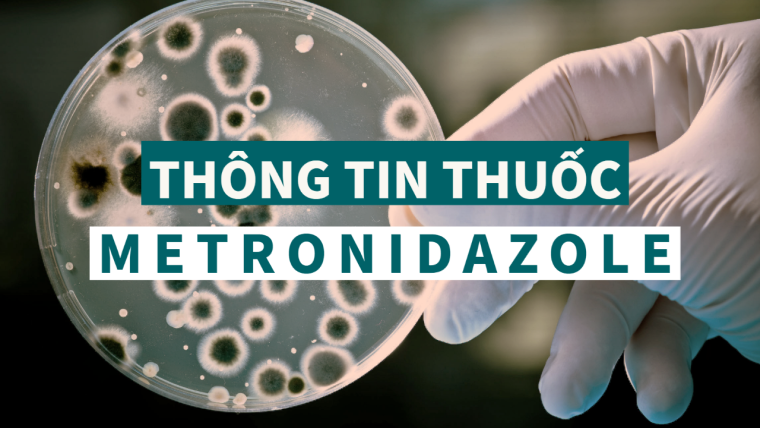
Metronidazole: Thông tin thuốc, chỉ định, chống chỉ định, tác dụng phụ và liều lượng điều trị bệnh

Mô tả
Metronidazole là một loại kháng sinh được sử dụng phổ biến, thuộc nhóm kháng sinh nitroimidazole. Nó thường được sử dụng để điều trị các bệnh nhiễm trùng đường tiêu hóa cũng như [bệnh trichomonas] và [bệnh giardia], và bệnh nhiễm trùng do ký sinh trùng. Đặc tính chống ký sinh trùng được bổ sung làm cho nó khác biệt với nhiều loại thuốc kháng khuẩn khác.
Cấu trúc hóa học của Metronidazole
Chỉ định
Metronidazole được chỉ định để điều trị bệnh [nhiễm Trichomonas] đã được xác nhận gây ra bởi Trichomonas vaginalis (ngoại trừ trong ba tháng đầu của thai kỳ) và bạn tình của bệnh nhân, [viêm âm đạo] do vi khuẩn, một số loại bệnh [giun chỉ] và các bệnh nhiễm trùng kỵ khí khác trên da và cấu trúc da, bụng, tim, cơ quan sinh sản, hệ thần kinh trung ương và hệ hô hấp. Một số cũng có thể có trong máu trong trường hợp [nhiễm trùng huyết]. Các bệnh nhiễm trùng phổ biến được điều trị bằng metronidazole là nhiễm trùng do vi khuẩn [Bacteroides], nhiễm trùng do Clostridium và nhiễm trùng Fusobacterium, cũng như nhiễm trùng Peptococcus và Peptostreptococcus.
Nó cũng được sử dụng ngoài nhãn trong điều trị [bệnh Crohn] và [bệnh trứng cá đỏ], [dự phòng sau phẫu thuật], và trong điều trị nhiễm [Helicobacter pylori]. Nó cũng đã được nghiên cứu trong việc [ngăn ngừa sinh non] và điều trị [bệnh nha chu].
Chống chỉ định
- [Quá mẫn] với metronidazole hoặc các dẫn xuất nitroimidazole khác.
- [Ba tháng đầu của thai kỳ].
- [Phản ứng tâm thần với Disulfiram]: Sử dụng metronidazole đường uống có liên quan đến các phản ứng loạn thần ở bệnh nhân nghiện rượu đang sử dụng đồng thời với disulfiram. Không dùng metronidazol cho bệnh nhân đã dùng disulfiram trong vòng hai tuần qua.
- [Rượu]: Sử dụng metronidazole đường uống có liên quan đến phản ứng giống disulfiram với rượu, bao gồm đau quặn bụng, buồn nôn, nôn, đau đầu và đỏ bừng. Ngừng uống rượu hoặc các sản phẩm có chứa propylene glycol trong và ít nhất ba ngày sau khi điều trị với metronidazole
Dược lực học
Metronidazole điều trị bệnh giun chỉ, trichomonas và bệnh giardia, có tác dụng cả kháng khuẩn và chống động vật nguyên sinh. Metronidazole là một phương pháp điều trị hiệu quả đối với một số bệnh nhiễm trùng do vi khuẩn kỵ khí. Metronidazole đã cho thấy hoạt tính kháng khuẩn chống lại phần lớn vi khuẩn kỵ khí bắt buộc, tuy nhiên, trong các nghiên cứu in vitro không cho thấy tác dụng đáng kể chống lại các vi khuẩn kỵ khí dễ nuôi hoặc các vi khuẩn hiếu khí bắt buộc. Sự khử nhóm nitro của metronidazol bởi các sinh vật kỵ khí có thể gây ra tác dụng độc tế bào kháng khuẩn của thuốc, gây tổn thương sợi DNA đối với vi khuẩn.
Cơ chế hoạt động
Cơ chế hoạt động chính xác của metronidazole chưa được xác định đầy đủ, tuy nhiên, có thể chất trung gian trong quá trình khử metronidazole chỉ được tạo ra bởi vi khuẩn kỵ khí và động vật nguyên sinh, liên kết với axit deoxyribonucleic và các protein vận chuyển điện tử của sinh vật, ngăn chặn axit nucleic tổng hợp. Sau khi dùng, metronidazol đi vào tế bào bằng cách khuếch tán thụ động. Sau đó, ferredoxin hoặc flavodoxin khử nhóm nitro của nó thành các gốc nitro. Khả năng oxy hóa khử của các phần vận chuyển điện tử của vi sinh vật kỵ khí hoặc vi sinh vật ưa phân tử làm cho metronidazole có tính chọn lọc đối với những sinh vật này, gây ra sự khử nhóm nitro, dẫn đến sản sinh các chất chuyển hóa độc hại. Chúng bao gồm N- (2-hydroxyetyl) axit oxamic và axetamit, có thể làm hỏng DNA của các sinh vật sao chép.
Thời gian bán hủy
Thời gian bán thải của metronidazole là 7,3 ± 1,0 giờ sau một liều 500mg IV duy nhất ở người khỏe mạnh.
Độc tính
LD50 đường uống của metronidazole ở chuột là 5000mg/kg
Thông tin quá liều
Các tác dụng ngoại ý có thể bị phóng đại khi dùng quá liều bao gồm bệnh thần kinh ngoại biên, nhiễm độc hệ thần kinh trung ương, co giật, tác dụng giống disulfiram (nếu kết hợp với rượu) nước tiểu sẫm màu, vị kim loại trong miệng, buồn nôn, khó chịu vùng thượng vị và chóng mặt, ngoài ra còn có giảm bạch cầu trung tính.
Không có thuốc giải độc đặc hiệu cho quá liều metronidazole.
Điều trị triệu chứng và hỗ trợ nên được áp dụng ngoài việc dùng than hoạt tính để loại bỏ thuốc chưa được hấp thu qua đường tiêu hóa. Ngoài các biện pháp trên, hãy liên hệ với trung tâm kiểm soát chất độc địa phương để biết thông tin cập nhật về việc quản lý quá liều metronidazole.
Phổ tác dụng
- Vi khuẩn và động vật nguyên sinh
- Vi khuẩn Helicobacter pylori
- Peptoclostridium difficile
Liều lượng
| Điều trị | Người lớn | Trẻ em |
| Nhiễm khuẩn/ Nhiễm trùng ổ bụng/ Viêm phúc mạc/ Áp xe gan/ Viêm xương khớp/ Viêm tủy xương/ Nhiễm trùng da và mô mềm/ Nhiễm trùng da và cấu trúc da/ Dự phòng nhiễm trùng tại vết thương | Khởi đầu: 15mg/kg IV x 1 lần/ngày; Duy trì: 7.5mg/kg IV x 4 lần/ngày; Thời gian: 7-10 ngày | 30-40mg/kg/ngày IV chia 3 lần/ngày |
| Bệnh lỵ amip | 750mg x 3 lần/ngày trong 5-10ngày | |
| Dự phòng phẫu thuật | 15mg/kg IV trong 30-60 phút trước phẫu thuật | Duy trì: 7.5mg/kg IV x 2-4 lần/ngày |
| Trichomoniasis | 375mg x 2 lần/ngày trong 7ngày | <45kg: 45mg/kg/ngày chia 3 lần/ngày trong 7 ngày |
| Nhiễm trùng âm đạo | 750mg x 1 lần/ngày trong 7ngày | <45kg: 15-25mg/kg/ngày chia 3 lần/ngày trong 7 ngày; >45kg: 500mg x 2 lần/ngày trong 7ngày |
| Viêm đại tràng giả mạc | 500mg x 3 lần/ngày trong 10-14ngày | |
| Viêm vùng chậu | 500mg x 2 lần/ngày trong 14 ngày | |
| Bệnh nhiễm khuẩn giardias | 500mg x 3 lần/ngày trong 5-7ngày | 5mg/kg x 3 lần/ngày trong 5-7 ngày |
| Dự phòng STD | 2g uống lần duy nhất | 2g uống lần duy nhất |
| Viêm niệu đạo do mô cầu | 2g uống lần duy nhất | 2g uống lần duy nhất |
| Balantidium coli | 500-750mg x 3 lần/ngày trong 5 ngày | 35-50mg/kg/ngày chia 3 lần/ngày trong 5 ngày |
| Dientamoeba fragilis | 500-750mg x 3 lần/ngày trong 10 ngày | 35-50mg/kg/ngày chia 3 lần/ngày trong 10 ngày |
| Mụn trứng cá | 1% thoa lớp mỏng lên mụn x 1 lần/ngày | 0.75% thoa lớp mỏng lên mụn x 2 lần/ngày |
| Nhiễm trùng đường âm đạo | 1.3% thoa lớp lên đường âm đạo x 1 lần/ngày trước khi ngủ | 1.3% thoa lớp lên đường âm đạo x 1 lần/ngày trước khi ngủ |
Tương tác thuốc
Disulfiram
Phản ứng loạn thần đã được báo cáo ở những bệnh nhân nghiện rượu đang sử dụng đồng thời metronidazole và disulfiram. Metronidazole không được dùng cho bệnh nhân đã dùng disulfiram trong vòng hai tuần qua (xem CHỐNG CHỈ ĐỊNH).
Đồ uống có cồn
Co thắt bụng, buồn nôn, nôn, đau đầu và đỏ bừng mặt có thể xảy ra nếu uống đồ uống có cồn hoặc các sản phẩm có chứa propylene glycol trong khi hoặc sau khi điều trị metronidazole (xem CHỐNG CHỈ ĐỊNH).
Warfarin và các thuốc chống đông máu đường uống khác
Metronidazole đã được báo cáo làm tăng tác dụng chống đông máu của warfarin và các thuốc chống đông máu coumarin đường uống khác, dẫn đến kéo dài thời gian prothrombin. Khi metronidazole được kê đơn cho bệnh nhân đang điều trị loại thuốc chống đông máu này, nên theo dõi cẩn thận thời gian prothrombin và INR.
Lithium
Ở những bệnh nhân ổn định khi dùng liều tương đối cao của lithi, liệu pháp metronidazol ngắn hạn có liên quan đến việc tăng lithi huyết thanh và trong một số trường hợp, có dấu hiệu ngộ độc lithi. Nồng độ lithi và creatinin huyết thanh nên được thu thập vài ngày sau khi bắt đầu dùng metronidazol để phát hiện bất kỳ sự gia tăng nào có thể xảy ra trước các triệu chứng lâm sàng của nhiễm độc lithi.
Busulfan
Metronidazole đã được báo cáo là làm tăng nồng độ busulfan trong huyết tương, có thể làm tăng nguy cơ ngộ độc busulfan nghiêm trọng. Metronidazole không nên dùng đồng thời với busulfan trừ khi lợi ích cao hơn nguy cơ. Nếu không có lựa chọn điều trị thay thế metronidazole và cần dùng đồng thời với busulfan về mặt y tế, nên theo dõi thường xuyên nồng độ busulfan trong huyết tương và nên điều chỉnh liều busulfan cho phù hợp.
Thuốc ức chế enzym CYP450
Việc sử dụng đồng thời các thuốc làm giảm hoạt tính của enzym gan microsome, chẳng hạn như cimetidine, có thể kéo dài thời gian bán thải và làm giảm độ thanh thải trong huyết tương của metronidazole.
Thuốc kích thích enzym CYP450
Việc sử dụng đồng thời các thuốc kích thích men gan ở microsome, chẳng hạn như phenytoin hoặc phenobarbital, có thể đẩy nhanh quá trình đào thải metronidazole, dẫn đến giảm nồng độ trong huyết tương; cũng đã được báo cáo làm giảm độ thanh thải của phenytoin.
Phụ nữa có thai và cho con bú
Tác dụng gây quái thai
Một nghiên cứu cho thấy tăng nguy cơ sứt môi, có hoặc không hở hàm ếch, ở trẻ sơ sinh tiếp xúc với metronidazole trong tử cung; tuy nhiên, những phát hiện này không được xác nhận. Ngoài ra, hơn mười thử nghiệm lâm sàng ngẫu nhiên có đối chứng với giả dược đã thu hút hơn 5000 phụ nữ mang thai để đánh giá việc sử dụng điều trị kháng sinh (bao gồm metronidazole) đối với bệnh viêm âm đạo do vi khuẩn về tỷ lệ sinh non.
Metronidazole đi qua hàng rào nhau thai và tác dụng của nó đối với sự hình thành cơ quan của bào thai người chưa được biết đến. Các nghiên cứu về khả năng sinh sản đã được thực hiện trên chuột cống, thỏ và chuột nhắt với liều lượng tương tự như liều lượng khuyến cáo tối đa cho người dựa trên so sánh diện tích bề mặt cơ thể. Không có bằng chứng về tác hại cho thai nhi do metronidazole.
Các bà mẹ cho con bú
Metronidazole có trong sữa mẹ với nồng độ tương tự như nồng độ huyết thanh của mẹ và nồng độ trong huyết thanh của trẻ sơ sinh có thể gần bằng hoặc tương đương với nồng độ điều trị của trẻ sơ sinh. Do khả năng gây khối u cho metronidazole trong các nghiên cứu trên chuột và chuột nhắt, nên quyết định ngừng cho con bú hay ngừng thuốc, có tính đến tầm quan trọng của thuốc đối với người mẹ. Ngoài ra, bà mẹ cho con bú có thể chọn cách hút và vắt bỏ sữa mẹ trong thời gian điều trị metronidazole, và trong 24 giờ sau khi liệu pháp kết thúc và cho trẻ bú sữa mẹ hoặc sữa công thức đã dự trữ.
Nguồn tham khảo:
- https://go.drugbank.com/drugs/DB00916
- https://www.drugs.com/dosage/metronidazole.html
- https://www.rxlist.com/flagyl-drug.htm